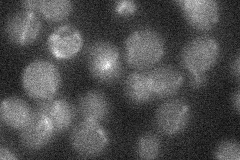
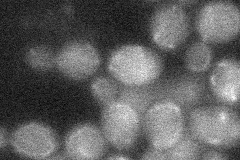
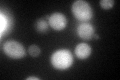
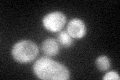
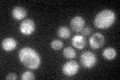

View description
Leucyl aminopeptidase yscIV (leukotriene A4 hydrolase) with epoxide hydrolase activity, metalloenzyme containing one zinc atom; green fluorescent protein (GFP)-fusion protein localizes to the cytoplasm and nucleus
Localization:
Intensity:
Fold change:
Significance:
-
C’ GFP library in SD

cytosol41.07 -
N' NOP1pr-GFP in SD

below threshold13.8122 -
N' TEF2pr-mCherry in SD

below threshold85.3324 -
N' NATIVEpr-GFP in SD
below threshold17.0778 -
N' TEF2pr-VC and Cyto-VN in SD
below threshold23.598 -
C’ GFP library in SD+DTT
cytosol60.381.46Yes -
C’ GFP library in SD+H2O2
cytosol51.961.26No -
C’ GFP library in Starvation Media
cytosol53.371.29No -
C’ GFP library on the background of Pup2-DaMP

cytosol -
C’ GFP library on the background of CCT mutant

cytosol53.12651.29328No
